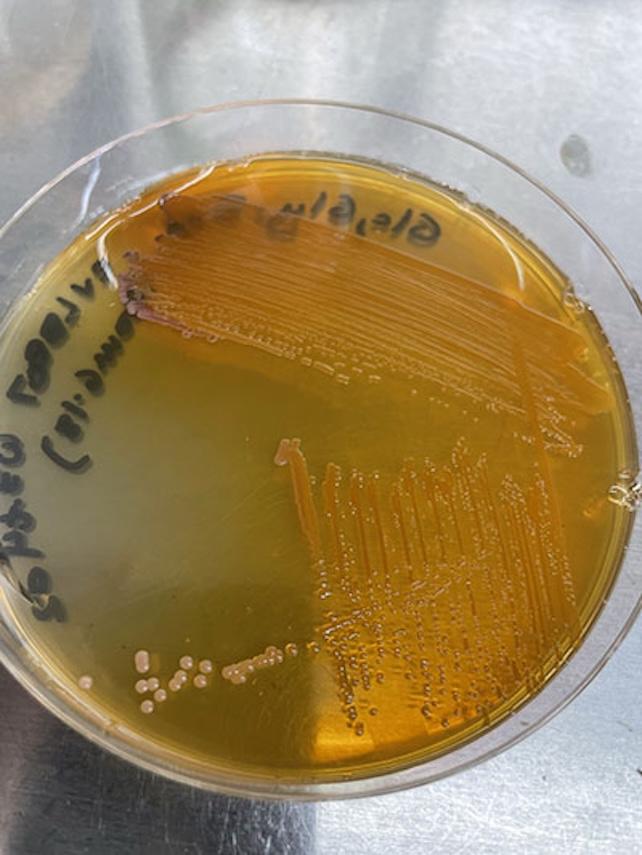
Bakterijos, Petri lėkštelėje gaminančios ksantommationą

Aštuonkojai ir kiti galvakojai yra tikri maskavimosi meistrai – jų spalvą keičianti oda leidžia gyvūnams beveik visiškai susilieti su aplinka. Mokslininkams pavyko žengti reikšmingą žingsnį link šios ypatingos savybės atkartojimo.
UC San Diego mokslininkų vadovaujama komanda sugebėjo masiškai išgauti svarbų pigmentą – ksantommationą, kuris randamas ryškiaspalvėje daugelio galvakojų odoje. Iki šiol šio junginio surinkimas iš gyvūnų ar sintezė laboratorijoje buvo nepraktiški ir neefektyvūs.
Tiesiogiai pigmento mokslininkai negamino – jie bioinžinerijos metodais pritaikė bakterijas, kad šios pačios pradėtų sintetinti ksantommationą. Mikroorganizmai buvo „įtikinti“ ne tik gaminti šią retą medžiagą, bet ir daryti tai itin našiai – iki 1 000 kartų efektyviau, nei ankstesniais metodais.
Lengvesnė prieiga prie ksantommationo gali padėti giliau ištirti galvakojų maskavimosi mechanizmus ir atskleisti daugiau šio įspūdingo gamtos reiškinio paslapčių. Tai taip pat gali atverti galimybes sukurti medžiagas, imituojančias aštuonkojų odos savybes.
Mikrobų gamyba – ateities pramonės kryptis
Šis tyrimas svarbus ne tik žmogaus „aštuonkojų supergalių“ paieškoms. Jis taip pat rodo, kokį potencialą turi mikroorganizmų pagrindu kuriama gamyba. Jei bakterijas pavyktų panašiai priversti efektyviai gaminti ir kitas chemines medžiagas, tai galėtų iš esmės pakeisti dabartinius pramoninius procesus, sumažinti priklausomybę nuo iškastinio kuro ir taršos.
„Sukūrėme naują metodą, kuris labai paspartino mūsų galimybes pirmą kartą pagaminti bakterijoje tam tikrą medžiagą – šiuo atveju ksantommationą,“ – aiškina tyrimo vyresnysis autorius, jūrų chemikas Bradley Moore iš Scripps okeanografijos instituto ir Kalifornijos universiteto San Diege.
„Šis natūralus pigmentas suteikia aštuonkojams ir kalmarams galimybę maskuotis – tai nuostabi supergalia. Mūsų pasiekimas, leidžiantis reikšmingai padidinti šios medžiagos gamybą, tėra tik pradžia,“ – priduria jis.

„Augimu susieta biosintezė“: kaip priversti bakterijas dirbti
Siekdami, kad bakterijos gamintų daug pigmento, mokslininkai pasitelkė naują metodą, kurį pavadino „augimu susieta biosinteze“. Jo esmė – susieti bakterijų išgyvenimą su ksantommationo gamyba, kad mikroorganizmai būtų „suinteresuoti“ sintetinti pigmentą.
„Šiai problemai spręsti reikėjo visiškai naujo požiūrio,“ – pasakoja pagrindinė tyrimo autorė Leah Bushin, vadovavusi darbui Moore laboratorijoje Scripps okeanografijos institute. „Iš esmės mes sugalvojome būdą, kaip apgauti bakterijas, kad jos gamintų daugiau mums reikalingos medžiagos.“
Bakterijos yra taupios ir vengia švaistyti resursus medžiagoms, kurios nėra būtinos jų išgyvenimui. Todėl tyrėjai sukūrė genetiškai modifikuotas „sergančias“ ląsteles, galinčias augti tik tuo atveju, jei jos nuolat gamina dvi medžiagas: ksantommationą ir skruzdžių rūgštį.
Skruzdžių rūgštis bakterijoms tarnavo kaip kuras. Kadangi kiekvienas naujas pigmento molekulės susidarymas buvo susietas su vienos skruzdžių rūgšties molekulės gamyba, bakterijos gaudavo tiek energijos, kiek reikėjo augimui – bet tik tuo atveju, jei gamino pigmentą. Taip buvo sukurtas savotiškas grįžtamojo ryšio ciklas, palaikantis intensyvią pigmento sintezę.
„Mes padarėme taip, kad šios biosintezės grandinės aktyvumas – junginio gamyba – būtų gyvybiškai būtinas organizmo išlikimui,“ – aiškina Bushin. „Jei organizmas negamina ksantommationo, jis paprasčiausiai neauga.“
Įspūdingi rezultatai ir naujos galimybės
Taikant šį metodą, pavyko gauti iki 3 gramų pigmento iš vieno litro auginimo terpės. Nors skaičiai gali atrodyti nedideli, tai gerokai viršija ankstesnius rezultatus: kiti metodai tetesudavo apie 5 miligramus litrui, pabrėžia tyrėjų komanda.
Pasak Bushin, rezultatai pasirodė labai greitai: „Tai buvo viena geriausių mano dienų laboratorijoje. Palikau eksperimentą per naktį, o ryte pamačiusi, kad bakterijos gamina daug pigmento, buvau neapsakomai laiminga. Tokios akimirkos ir yra priežastis, kodėl užsiimu mokslu.“
Be grįžtamojo ryšio ciklo, stiprinančio pigmento gamybą, mokslininkai papildomai optimizavo sukurtas bakterijų linijas taikydami adaptyvios laboratorinės evoliucijos metodus. Jie taip pat naudojo bioinformatikos įrankius efektyvumui didinti bei pritaikė mikroorganizmus taip, kad šie pigmentą sugebėtų sintetinti iš vienintelio mitybos šaltinio, pavyzdžiui, gliukozės.
Biogamybos ateitis
Bendraautorius, UC San Diego bioinžinierius Adam Feist, teigia, kad šio projekto rezultatai rodo milžinišką tokio požiūrio potencialą.
„Šis projektas leidžia pažvelgti į ateitį, kurioje biologija, pasitelkdama pažangią automatizaciją, duomenų integraciją ir kompiuterinį projektavimą, suteiks galimybę tvariai gaminti vertingus junginius ir medžiagas,“ – sako Feist.
„Parodėme, kaip galima paspartinti inovacijas biogamyboje, kai inžinieriai, biologai ir chemikai dirba kartu, naudodami pažangiausius kamienų modifikavimo metodus ir per palyginti trumpą laiką sukuria bei optimizuoja visiškai naują produktą.“










